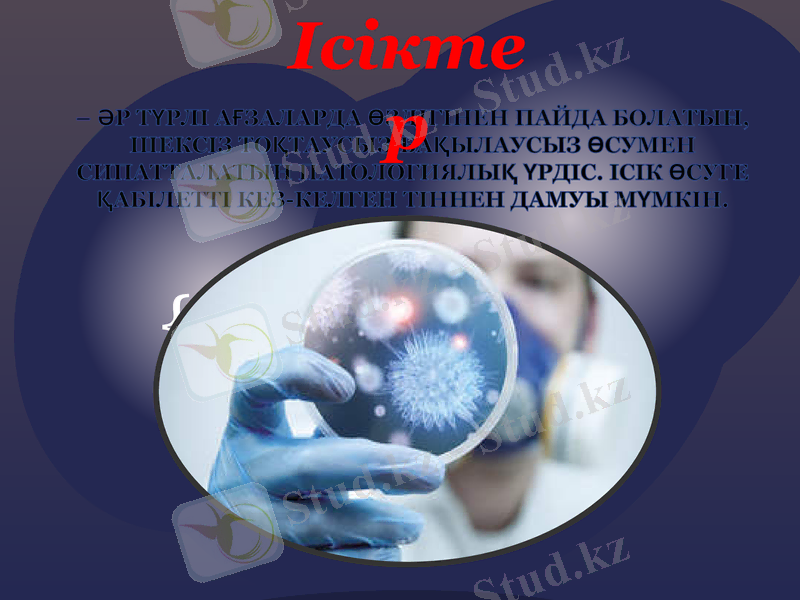
Slide 3

Ісіктер: анықтамасы, морфологиясы, патогенезі, жіктелуі және зерттеу әдістері



Қазақстан Республикасы Білім және ғылым министрлігі Семей қаласы Шәкәрім атындағы мемлекеттік университеті
СӨЖ
Тақырыбы: Ісіктер
Семей, 2018 жыл

Жоспар:
Кіріспе бөлім
Негізгі бөлім
1. Ісік үрдісі анықтамасы мен мәні
2. Ісіктің морфологиялық көріністері мен құрылысы, өсу ерекшеліктері
3. Ісіктердің патогенезі
4. Ісіктердің жіктелуі
5. Қатерлі және қатерсіз ісіктер
6. Зерттеу әдістері
Пайдаланған әдебиеттер тізімі
- әр түрлі ағзаларда өздігінен пайда болатын, шексіз тоқтаусыз, бақылаусыз өсумен сипатталатын патологиялық үрдіс. Ісік өсуге қабілетті кез-келген тіннен дамуы мүмкін.
Ісіктер

Ісіктердің пайда болу себептері өте көп, олар әлі де болса ақырына дейін зерттелмеген. Ракты тексеруші Халықаралық қоғамның анықтауы бойынша адам рагының 80-90 пайызы қоршаған ортада таралған әртүрлі (химиялық, физикалық және биологиялық) ықпалдардың әсеріне байланысты.
1775 жылы Англияда Персивал Потт мұржа тазалайтындардың обырын хабарлады: бала күнінен көп жылдар түтін шығатын мұржаларды тазалайтын адамдардың ұма терісінде, санының және құрсақ терілерінде обыр ісігі пайда болатыны байқалған. Бұл обырдың себебі пештің күйесі болады деген пікір айтылды. Осыдан кейін көп зерттеушілер обыр ісігін жануарлардың терісіне тас көмір қара майын жағу арқылы тәжірибеде алуға кірісті.
Тек 1918 жылы жапон зерттеушілері Ямагива мен Ишикава осы жолмен қоянның құлағында тері обырын алды. Осыдан бастап химиялық канцерогенезді жүйелі түрде зерттеу басталды. Артынан әртүрлі химиялық заттардың әсерлерінен ісіктің басқа түрлері де дамитыны белгілі болды. Көптеген кәсіптік рактар да әртүрлі химиялық заттардың әсерінен дамиды. Мысалы, хош иісті аминдерге жататын анилин, бензидин, 2-нафтиламинмен жұмыс істейтін адамдардың көпшілігінде 5 жылдан кейін қуық рагы пайда болады. Ренгенологтарда, басқа дәрігерлерге қарағанда тері рагы 8 есе жиі ұшырайды. Этилнитроздық аминдер бүйрктің, жүйке жүйесінің рагына, диэтилнитроздық аминдер - бауыр рагына соқтырады.


Ісіктердің пайда болу себептері өте көп, олар әлі де болса ақырына дейін зерттелмеген. Ракты зерттеуші Халықаралық қоғамның анықтауы бойынша адам рагының 80-90 проценті қоршаған ортада таралған канцерогендік (рак тудырушы) заттардың әсеріне байланысты.
Әсер ету механизмдеріне қарап химиялық концерогендер екі топқа бөлінеді:
1) Жасушалардың ДНҚ-сымен тікелей әсерлесетін толық концероген
2) Организмдегі химиялық реакцияларға пайланысты пайда болған метоболиттері арқылы әсер ететін жанама концерогендер, оларды проканцерогендер деп те атайды.

Физикалық канцерогендер:
Сәулелі (ультрафиолетті) радиация- тері ісігі, тері меланомасы;
Иондаушы радиация- лейкоз

Ісік туындататын вирустар үш сатыда әсер етеді:
1) жасуша ішіне еніп, онда ДНҚ молекуласымен бірігіп кетеді де, жасушаның тектік ақпаратын өзгертеді;
2) өзгерген тектік ақпарат бойынша онконәруыздар мен РНҚ түзілуін арттырады;
3) онконәруыздар жасушаның шексіз бөлініп көбеюін арттырып, ісік жасушасына айналдырады.

Ісіктердің патогенезі:
канцерогенді агенттердің немесе тұқымқуалаушылық патологиялардың әсерінен геномдағы соматикалық жасушалардың өзгеруі;
жасушалық онкогендердің белсендірілуі және антионкогендердің супрессиясы.
жасушаның ісікті трансформациясы және оның бақылаусыз шексіз өсу қабілетіне ие болуы.


ІСІКТІҢ ЖІКТЕЛУІ
Жеке ағзаға тән емес эпителилік ісіктер
Жеке ағзаға тән эпителилік ісіктер
Мезенхималық ісіктер
Меланинтүзуші тін ісіктері
Нерв жүйесі және ми қабықтарының ісіктері
Қан жүйесінің ісіктері
Тератомалар

Ісіктің морфологиялық көріністері мен құрылысы. Өсу ерекшеліктері
Ісіктің қай тіннің немесе ағзадан өсуіне байланысты оның сыртқы көрінісі әр түрлі. Ісік ағңза қуысына қарай немесе терінің сыртында полип тәрізді жіңішке сабаққа ілініп тұрса, оны экзофитті өсу дейді. Егер ісік қуыс ағзаның қабырғасына немесе басқа ағзалардың ішіне қарай өссе, оны эндофитті өсу деп атайды. Ісік көбінесе үлкенді кішілі түйін түрінде өседі, оның көлемі қай жерде өсуіне байланысты. Ал ісіктің жұмсақ немесе қатты болуы оның паренхимасы мен стромасының арақатынасына байланысты.

Барлық ісіктерді гистологиялық құрылысына, клиникалық көріністеріне қарап бөлінеді:
Қатерсіз Қатерлі
Жергілікті тінді бұзып өсуші

Жергілікті тінді бұзып өсетін ісіктер
Бұлар қатерлі ісіктер тобына жатқанмен, метастаз бермейді, сондықтан оларды сылып тастау мүмкін. мысалы, терідегі базалиома ісігі осы ісіктер қатарына жатады.

Қатерлі және қатерсіз ісіктердің сипаттамасы
Өсу ерекшеліктері
Қатерсіз ісіктер
Қатерлі ісіктер
Өсу түрі
Экспансиялық (ісік шекара-сы анық, айналасындағы тін-ді ығыстырып өседі)
Инвазиялық (ісік шекарасы анық көрінбейді, айналасын-дағы тінге сіңіп өседі)
Өсу жылдамдығы
Баяу
Тез
Тіндік атипизм
Болады
Болады
Жасушалық
Болмайды
Болады
Атипизм
Болмайды
Жиі байқалады
Метастаздар
Төмен
Өте жоғары, атипиялық митоздар көп
Митоздық белсенділігі
Жоғары
Өте төмен кейде мүлде ұқсамайды
Өзі дамыған тінге гистологиялық ұқсастығы
Өте сирек
Жиі
Қайталануы
Организмге әсері
Шамалы
Өте жаман көбінесе интоксикация белгілері, кахексия дамиды

Әдетте ұзақ уақыт өседі және организмді аса қауіпті өзгерістерге ұшыратпайды. Оларға негізінен тіндік атипизм тән. Тіндік атипизмге ісік құрамындағы паренхима мен строма арақатынастарының бұзылуы, строманы түзуші дәнекер талшықтарының әр түрлі жуандықта болуы немесе олардың түрлі бағытта ретсіз орналасуы, қан тамырларының бір жерде көп, екінші жерде аз болуы және т. б кіреді. Бірақ жасушалар түзілісінде өзгерістер болмайды.
Қатерсіз ісіктер

Қатерсіз ісіктер
ЕРЕКШЕЛІК-ТЕРІ
құрылымы қалыпты жасушаларға ұқсас келеді
ісік жасушалары дамыған және сараланған
айқындалған құрылымды атипизм
алып тастағанда қайтадан өспейді
Метастаздану болмайды
клиникалық көріністері жағымды
Кахексия тудырмайды және өлімге әкелмейді.
капсула түзіп өседі

Мезенхимадан өсетін қатерcіз ісіктер
Фиброма жетілген талшықты дәнекер тіннен өсетін қатерсіз ісік. Ол теріде, теріасты шелінде, сүт безінде, жатырда, бұлшықет аралығында өсіп, бірте-бірте үлкейіп көлденеңі 4-5 см жетеді

Липома - май тінінің қатерсіз ісігі. Ол кесіп қарағанда сары немесе ақшыл сары түсті. Липома көлемі мен пішіні әртүрлі май клеткаларынан түзілген. Егер маймен бірге дәнекер тін өсіп кетсе ісікті фибролипома деп атайды. Липома құрамында қан жасаушы элементтер болса оны миелолипома дейді.
Лейомиома - бірыңғай салалы бұлшықет ісігі, көбінесе жатырда, асқазан-ішек жолдарында кездеседі. Ісік құрамында дәнекер тін басым болса, ол ісік фибромиома деп, қан тамырлары көп болса - ангиомиома деп аталады.

Гибернома қоңыр май тәрізді өте сирек кездесетін ісік. Қоңыр май қалдық-тары ұшырайтын жерлерде: омыртқа, бүйрек, бүйрекүсті безі айналасында, жауырын аралығында, мойында, қолтық астында дамиды.

Эпителийден пайда болатын арнайы даму орны жоқ қатерсіз ісіктерге папиллома мен аденома жатады.
Папиллома
Папиллома (латынша papilla - бүртік) жалпақ және өтпелі эпителийден өсіп шығатын ісік. Ол теріде, ауыз, мұрын қуысында, көмейде, бүйрек астауында, қуықта, сүт бездерінің өзектерінде, ми қарыншаларының ішінде өседі. Папиллома көлденеңі 1 сантиметрге дейін болған түінше түрінде кейде сабақшаға ілінген полип тәрізді терінің не шырышты қабықтарының үстінде жайғасатын ісік.
Аденома
Аденома - безді ағзалар эпителиінен, олардың өзектерінен өсетін безді ісік. Ол айналасындағы тіндерден жақсы шекараланған, үлкендігі бірнеше миллиметр-ден, ондағы сантиметрге жететін, жұмсақ ісік. Аденомалар өсіп шыққан жеріндегі тіндерге ұқсас құрылымдар түзеді. Егер аденома құрамында эпителийден гөрі дәнекер тін өсуі басым болса, бұл ісікті фиброаденома деп атайды.


ҚАТЕРЛІ ІСІКТЕР

Оларға негізінен жасушалық атипизм тән. Оларды түзуші жасушалар өзі өсіп шыққан ағза не тін жасушаларынан өзгеше болып гетерологиялық ісіктер қатарына жатады. Қатерлі ісік сылып тастағаннан кейін де қайта өсуі мүмкін.
Қатерлі ісік айналасындағы тіндерге сіңе өсіп, әуел бастан метастаз береді. Метастаз деп ісік жасушаларының алғашқы ісік ошағынан бөлініп шығып басқа бір ағзаларда жаңа ісік түйінін түзуін айтады. Метастаз дамуы өте күрделі құбылыс, ол бірнеше кезеңдерден тұрады.

Е Р Е К Ш Е Л І К Т Е Р І
инфильтрацияланған өспе
капсуласы болмайды
жасушалық анаплазия
жетілмеген жасушалар
- Іс жүргізу
- Автоматтандыру, Техника
- Алғашқы әскери дайындық
- Астрономия
- Ауыл шаруашылығы
- Банк ісі
- Бизнесті бағалау
- Биология
- Бухгалтерлік іс
- Валеология
- Ветеринария
- География
- Геология, Геофизика, Геодезия
- Дін
- Ет, сүт, шарап өнімдері
- Жалпы тарих
- Жер кадастрі, Жылжымайтын мүлік
- Журналистика
- Информатика
- Кеден ісі
- Маркетинг
- Математика, Геометрия
- Медицина
- Мемлекеттік басқару
- Менеджмент
- Мұнай, Газ
- Мұрағат ісі
- Мәдениеттану
- ОБЖ (Основы безопасности жизнедеятельности)
- Педагогика
- Полиграфия
- Психология
- Салық
- Саясаттану
- Сақтандыру
- Сертификаттау, стандарттау
- Социология, Демография
- Спорт
- Статистика
- Тілтану, Филология
- Тарихи тұлғалар
- Тау-кен ісі
- Транспорт
- Туризм
- Физика
- Философия
- Халықаралық қатынастар
- Химия
- Экология, Қоршаған ортаны қорғау
- Экономика
- Экономикалық география
- Электротехника
- Қазақстан тарихы
- Қаржы
- Құрылыс
- Құқық, Криминалистика
- Әдебиет
- Өнер, музыка
- Өнеркәсіп, Өндіріс
Қазақ тілінде жазылған рефераттар, курстық жұмыстар, дипломдық жұмыстар бойынша біздің қор #1 болып табылады.



Ақпарат
Қосымша
Email: info@stud.kz